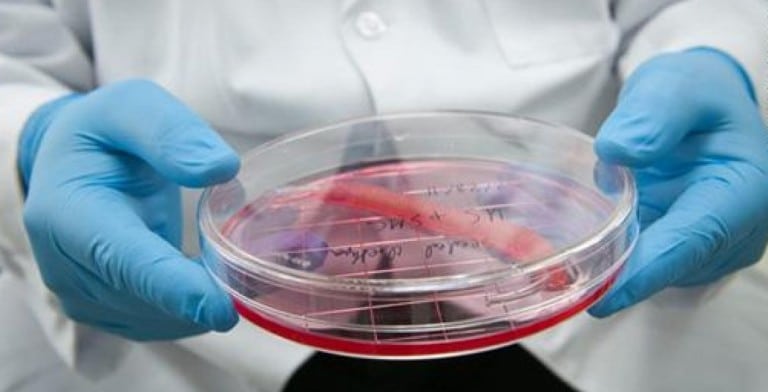

Objavljena nova, iznimno detaljna fotografija Mliječne staze
28 veljače, 2016
Gledajući u noćno nebo, čak i u područjima bez svjetlosnog zagađenja, možemo vidjeti tek mali dio zvijezda i ostalih nebeskih pojava. No, zahvaljujući naporima znanstvenika…